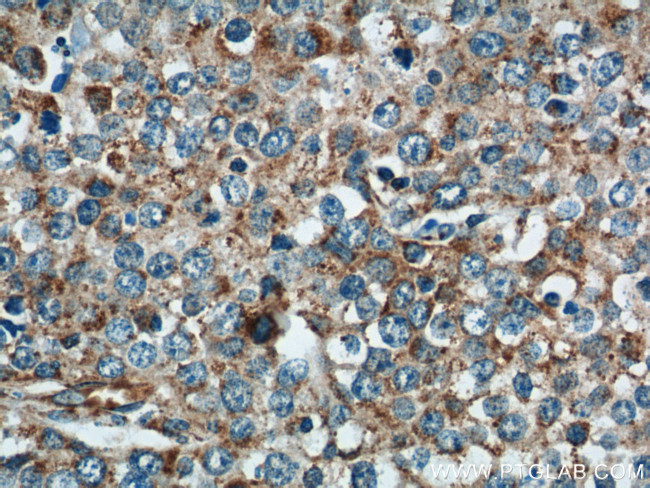
NDUFV1 Antibody in Immunohistochemistry (Paraffin) (IHC (P))

Search
Proteintech
NDUFV1 Polyclonal Antibody
{{$productOrderCtrl.translations['antibody.pdp.commerceCard.promotion.promotions']}}
{{$productOrderCtrl.translations['antibody.pdp.commerceCard.promotion.viewpromo']}}
{{$productOrderCtrl.translations['antibody.pdp.commerceCard.promotion.promocode']}}: {{promo.promoCode}} {{promo.promoTitle}} {{promo.promoDescription}}. {{$productOrderCtrl.translations['antibody.pdp.commerceCard.promotion.learnmore']}}
产品信息
11238-1-AP
种属反应
已发表种属
宿主/亚型
分类
类型
抗原
偶联物
形式
浓度
规格
纯化类型
保存液
内含物
保存条件
运输条件
产品详细信息
Immunogen sequence: NADEGEPGT CKDREILRHD PHKLLEGCLV GGRAMGARAA YIYIRGEFYN EASNLQVAIR EAYEAGLIGK NACGSGYDFD VFVVRGAGAY ICGEETALIE SIEGKQGKPR LKPPFPADVG VFGCPTTVAN VETVAVSPTI CRRGGTWFAG FGRERNSGTK LFNISGHVNH PCTVEEEMSV PLKELIEKHA GGVTGGWDNL LAVIPGGSST PLIPKSVCET VLMDFDALVQ AQTGLGTAAV IVMDRSTDIV KAIARLIEFY KHESCGQCTP CREGVDWMNK VMARFVRGDA RPAEIDSLWE ISKQIEGHTI CALGDGAAWP VQGLIRHFRP ELEERMQRFA QQHQARQAAS (116-464 aa encoded by BC015645)
靶标信息
NDUFV1 is the 51-kD subunit of complex I (NADH:ubiquinone oxidoreductase) of the mitochondrial respiratory chain.The NDUFV1 gene encodes the 51-kD subunit of complex I (NADH:ubiquinone oxidoreductase) of the mitochondrial respiratory chain.
仅用于科研。不用于诊断过程。未经明确授权不得转售。
生物信息学
蛋白别名: 51 kda flavoprotein; CI-51kD; complex I 51 kda subunit; complex I 51kDa subunit; complex I, mitochondrial respiratory chain; Complex I-51kD; mitochondrial NADH dehydrogenase ubiquinone flavoprotein 1; mitochondrial NADH:ubiquinone oxidoreductase 51 kda subunit; NADH dehydrogenase (ubiquinone) flavoprotein 1, 51kDa; NADH dehydrogenase [ubiquinone] flavoprotein 1, mitochondrial; NADH dehydrogenase flavoprotein 1; NADH dehydrogenase flavoprotein 1; 24 kDa (FP); NADH-ubiquinone oxidoreductase 51 kDa subunit; NDUFV1; unnamed protein product
基因别名: CI-51K; CI-51kD; CI51KD; MC1DN4; NDUFV1; UQOR1
UniProt ID: (Human) P49821, (Mouse) Q91YT0
Entrez Gene ID: (Human) 4723, (Mouse) 17995, (Rat) 293655